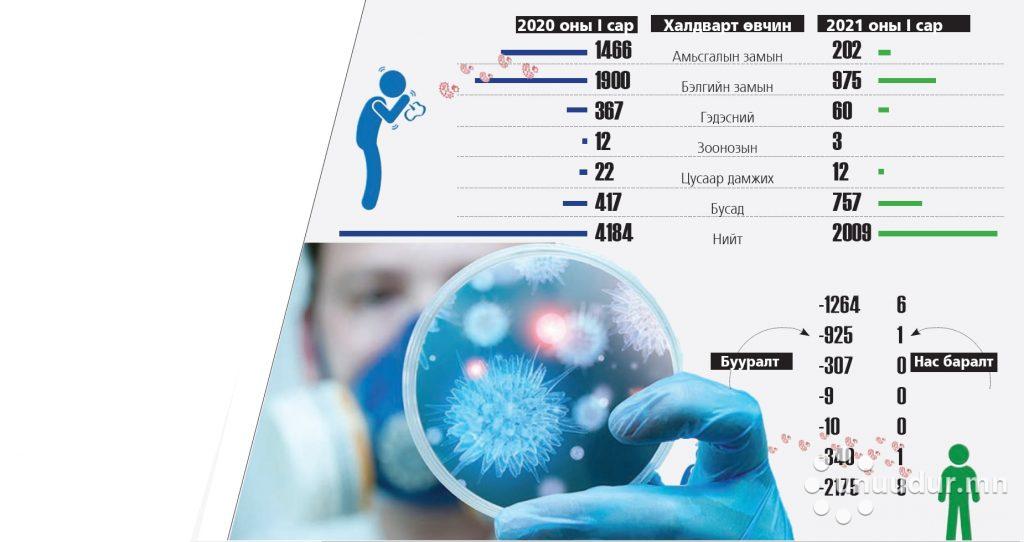

Хүн амын эрүүл мэндийн 2021 оны эхний сарын үзүүлэлтийг Эрүүл мэндийн хөгжлийн төвөөс тодрууллаа. Өнгөрсөн сард улсын хэмжээнд 2009 хүн 16 төрлийн халдварт өвчинд өртжээ. Энэ нь өмнөх жилийн мөн үеийнхээс 2175 тохиолдлоор буурсан үзүүлэлт юм байна. Нярайн нянгийн гаралтай үжил, коронавирусийн халдвар 2-564-өөр нэмэгдсэнээс бусад өвчлөл 1-1128 тохиолдлоор буурсан аж. Халдварт өвчнөөр найман хүн нас барсны зургаа нь сүрьеэ, нэг нь төрөлхийн тэмбүү, бас нэг нь “Ковид-19”-ийн улмаас энджээ. Ингэснээр халдварт өвчнөөр нас барсан хүний тоо өнгөрсөн оны нэгдүгээр сарынхаас зургаагаар цөөрсөн байна. Тэгвэл амьсгалын замын халдварт өвчинд 202 хүн өртсөн нь 2020 оныхоос 7.3 дахин буурсан үзүүлэлт аж. Бэлгийн замын халдварт өвчинд 48.7 хувиар буурсан эерэг мэдээ байна. Халдварт өвчин ийнхүү буурахад хөл хорионы дэглэм голлон нөлөөлсөн гэж албаныхан хэллээ.